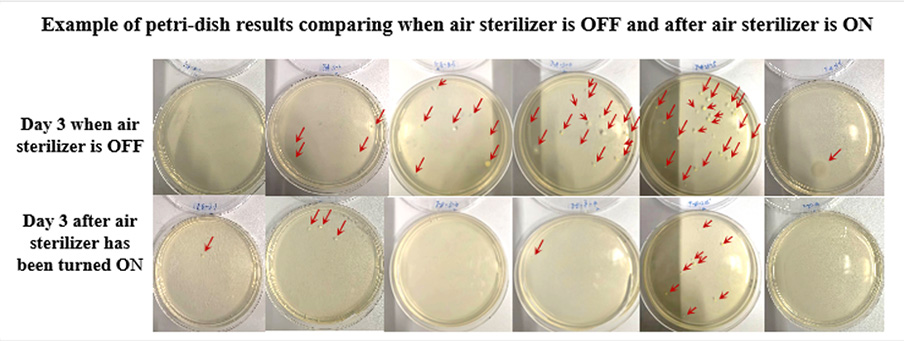

Views: 0 Author: Site Editor Publish Time: 2025-02-20 Origin: Site
Background:
Tsim Sha Tsui Centre is a famous commercial real estate in Hong Kong, located at 66 Mody Road, Tsim Sha Tsui. It is connected to Empire Centre by a pedestrian bridge and is adjacent to MTR Tsim Sha Tsui Station and Tsim Sha Tsui East Station, as well as the Star Ferry Island Line pier. As a world trade port and an important foreign trade city in China, Hong Kong attaches importance to public health requirements especially after the COVID-19 break and the demand for virus disinfection and sterilization and disease prevention from all walks of life is increasing sharply. As a famous commercial real estate in Hong Kong, Tsimshatsui Center conducts increasing strict and scientific management of public health. therefore, Tsimshatsui Center has taken a series of innovative measures, including intelligent temperature monitoring system, deep ultraviolet air disinfection machine, etc., to ensure a safe and healthy shopping environment for customers.
Pain points:
1. The mall receives a large number of customers and employees every day, with high personnel density and high turnover. Microorganisms such as bacteria and viruses may exist in the air. If not disinfected and sterilized in a timely and effective manner, they may spread through respiratory and other pathways, leading to cross infection between customers and employees and affecting their health.
2. Air disinfection and sterilization are important components of public health management. As a public place, Tsim Sha Tsui Centre needs to comply with relevant public health standards and regulations to ensure strong management of public health.
Solution:
During the installation process, we fully considered the actual air conditions in Tsim Sha Tsui Center. To ensure the effectiveness and coverage of the disinfection machine, we chose to install an air disinfection machine Q6060-A in the conference room and tested its disinfection effect on site.
Introducing MASSPHOTON deep ultraviolet air sterilizer: It uses the independently developed deep ultraviolet LED digital disinfection technology RayOnClean™, which can achieve more efficient sterilization of indoor air, effectively eliminate viruses, bacteria and other microorganisms, remove formaldehyde and allergens, thereby improving air quality.

Effect:
We conducted rigorous field tests in various scenarios in the conference room, and the tests covered the daily use of the conference room. By comparing the air quality data at different time periods before and after the sterilizer was installed, the results showed that after the sterilizer was started, the number of bacteria in the air dropped significantly, and the disinfecting rate reached an average of 61.62% for three consecutive days.